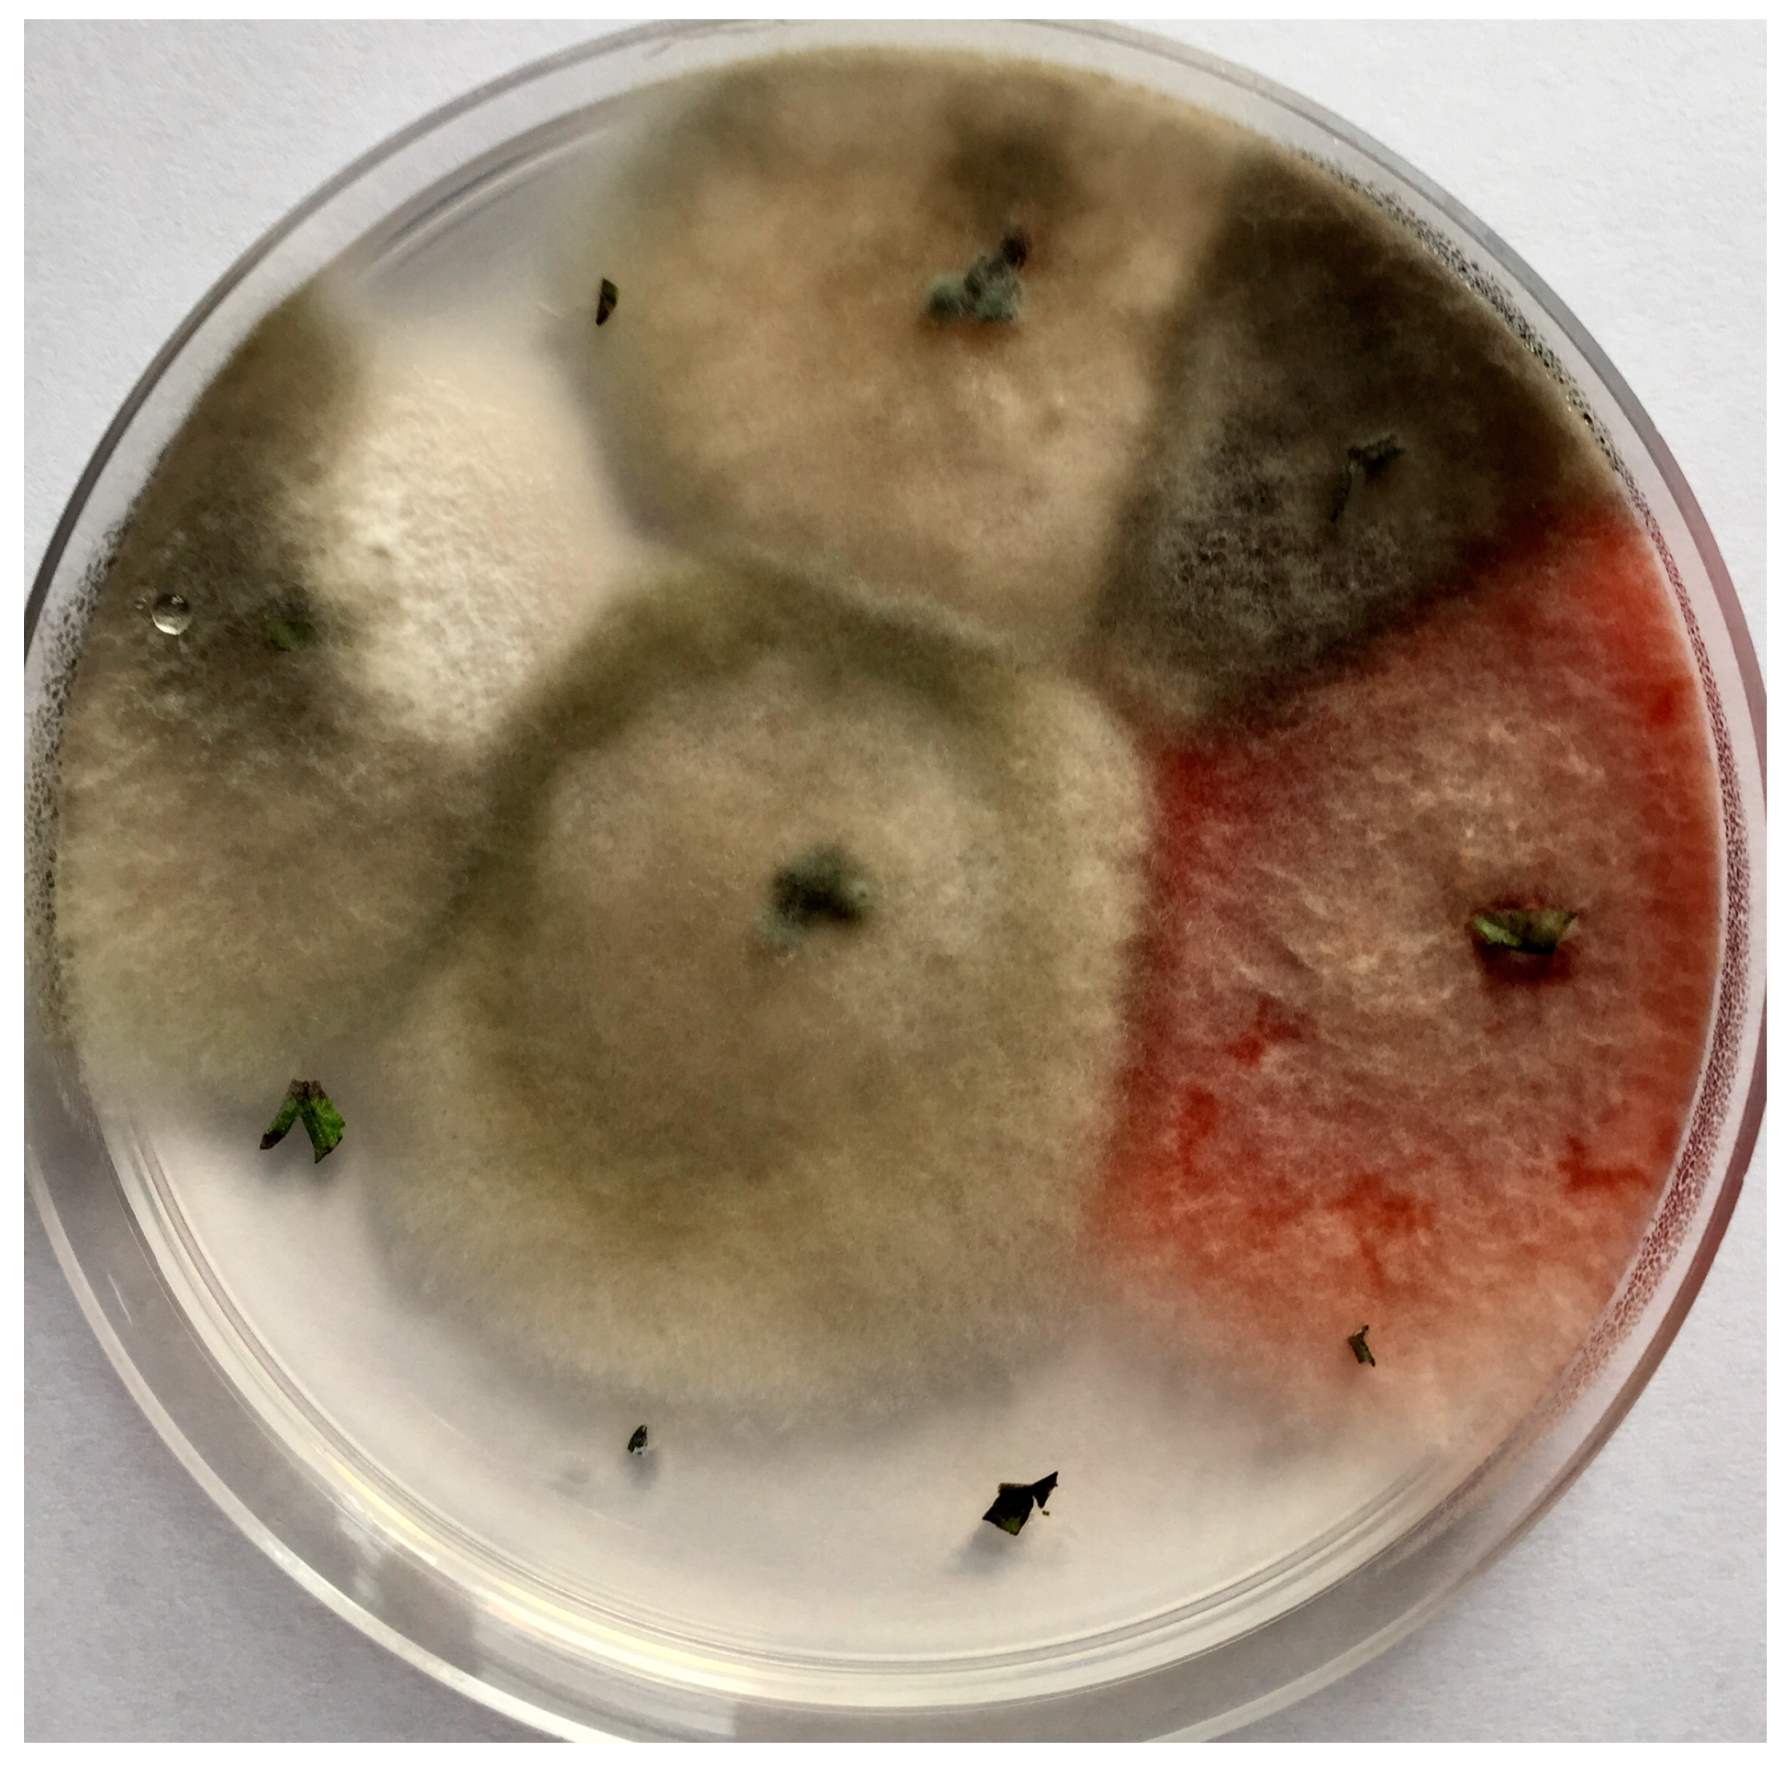
Agriculture 10 00543 g001

Bioactive Products from Endophytic Fungi of Sages (Salvia spp.)
Abstract
1. Introduction
2. Salvia: The Largest Genus of Lamiaceae
3. Ecology and Occurrence
4. Biochemical Properties
5. Biotechnological Implications
5.1. Endophytic Fungi as In Vitro Production Platforms for Plant Secondary Metabolites
5.2. Endophytic Fungi as Biotic Elicitors
5.3. Biotransformation/Detoxication Abilities of Endophytic Fungi
6. Conclusions
Author Contributions
Funding
Conflicts of Interest
References
- Gouda, S.; Das, G.; Sen, S.K.; Shin, H.S.; Patra, J.K. Endophytes: A treasure house of bioactive compounds of medicinal importance. Front. Microbiol. 2016, 7, 1538. [Google Scholar] [CrossRef] [PubMed]
- Nicoletti, R.; Fiorentino, A. Plant bioactive metabolites and drugs produced by endophytic fungi of Spermatophyta. Agriculture 2015, 5, 918–970. [Google Scholar] [CrossRef]
- Jia, M.; Chen, L.; Xin, H.L.; Zheng, C.J.; Rahman, K.; Han, T.; Qin, L.P. A friendly relationship between endophytic fungi and medicinal plants: A systematic review. Front. Microbiol. 2016, 7, 906. [Google Scholar] [CrossRef] [PubMed]
- Drew, B.T.; González-Gallegos, J.G.; Xiang, C.L.; Kriebel, R.; Drummond, C.P.; Walker, J.B.; Sytsma, K.J. Salvia united: The greatest good for the greatest number. Taxon 2017, 66, 133–145. [Google Scholar] [CrossRef]
- Will, M.; Claßen-Bockhoff, R. Time to split Salvia s.l. (Lamiaceae)—New insights from Old World Salvia phylogeny. Mol. Phylogenet. Evol. 2017, 109, 33–58. [Google Scholar] [CrossRef]
- Jassbi, A.R.; Zare, S.; Firuzi, O.; Xiao, J. Bioactive phytochemicals from shoots and roots of Salvia species. Phytochem. Rev. 2016, 15, 829–867. [Google Scholar] [CrossRef]
- Jiang, Z.; Gao, W.; Huang, L. Tanshinones, critical pharmacological components in Salvia miltiorrhiza. Front. Pharmacol. 2019, 10, 202. [Google Scholar] [CrossRef]
- Cao, E.H.; Liu, X.Q.; Wang, J.J.; Xu, N.F. Effect of natural antioxidant tanshinone II-A on DNA damage by lipid peroxidation in liver cells. Free Radic. Biol. Med. 1996, 20, 801–806. [Google Scholar] [CrossRef]
- Lee, D.S.; Lee, S.H.; Noh, J.G.; Hong, S.D. Antibacterial activities of cryptotanshinone and dihydrotanshinone i from a medicinal herb, Salvia miltiorrhiza Bunge. Biosci. Biotechnol. Biochem. 1999, 63, 2236–2239. [Google Scholar] [CrossRef]
- Kim, E.J.; Jung, S.N.; Son, K.H.; Kim, S.R.; Ha, T.Y.; Park, M.G.; Jo, I.G.; Park, J.G.; Wonchae, C.; Kim, S.S.; et al. Antidiabetes and antiobesity effect of cryptotanshinone via activation of AMP-activated protein kinase. Mol. Pharmacol. 2007, 72, 62–72. [Google Scholar] [CrossRef]
- Jang, S.I.; Jeong, S.I.; Kim, K.J.; Kim, H.J.; Yu, H.H.; Park, R.; Kim, H.M.; You, Y.O. Tanshinone IIA from Salvia miltiorrhiza inhibits inducible nitric oxide synthase expression and production of TNF-α, IL-1β and IL-6 in activated RAW 264.7 cells. Planta Med. 2003, 69, 1057–1059. [Google Scholar] [CrossRef] [PubMed]
- Wang, X.; Wei, Y.; Yuan, S.; Liu, G.; Lu, Y.; Zhang, J.; Wang, W. Potential anticancer activity of tanshinone IIA against human breast cancer. Int. J. Cancer 2005, 116, 799–807. [Google Scholar] [CrossRef] [PubMed]
- Tan, R.X.; Zou, W.X. Endophytes: A rich source of functional metabolites. Nat. Prod. Rep. 2001, 18, 448–459. [Google Scholar] [CrossRef] [PubMed]
- Faeth, S.H.; Fagan, W.F. Fungal endophytes: Common host plant symbionts but uncommon mutualists. Integr. Comp. Biol. 2002, 42, 360–368. [Google Scholar] [CrossRef]
- Arnold, A.E. Understanding the diversity of foliar endophytic fungi: Progress, challenges, and frontiers. Fungal Biol. Rev. 2007, 21, 51–66. [Google Scholar] [CrossRef]
- Salvatore, M.M.; Andolfi, A.; Nicoletti, R. The thin line between pathogenicity and endophytism: The case of Lasiodiplodia theobromae. Agriculture 2020, 10, 488. [Google Scholar] [CrossRef]
- Wang, Y.; Dai, C.C. Endophytes: A potential resource for biosynthesis, biotransformation, and biodegradation. Ann. Microbiol. 2011, 61, 207–215. [Google Scholar] [CrossRef]
- Rodriguez, R.J.; White, J.F.; Arnold, A.E.; Redman, R.S. Fungal endophytes: Diversity and functional roles. New Phytologist. 2009, 182, 314–330. [Google Scholar] [CrossRef]
- Rodriguez, R.; Redman, R. More than 400 million years of evolution and some plants still can’t make it on their own: Plant stress tolerance via fungal symbiosis. J. Exp. Bot. 2008, 59, 1109–1114. [Google Scholar] [CrossRef]
- Sun, J.; Xia, F.; Cui, L.; Liang, J.; Wang, Z.; Wei, Y. Characteristics of foliar fungal endophyte assemblages and host effective components in Salvia miltiorrhiza Bunge. Appl. Microbiol. Biotechnol. 2014, 98, 3143–3155. [Google Scholar] [CrossRef]
- Chen, H.; Wu, H.; Yan, B.; Zhao, H.; Liu, F.; Zhang, H.; Sheng, Q.; Miao, F.; Liang, Z. Core microbiome of medicinal plant Salvia miltiorrhiza seed: A rich reservoir of beneficial microbes for secondary metabolism? Int. J. Mol. Sci. 2018, 19, 672. [Google Scholar] [CrossRef] [PubMed]
- Teimoori-Boghsani, Y.; Ganjeali, A.; Cernava, T.; Müller, H.; Asili, J.; Berg, G. Endophytic fungi of native Salvia abrotanoides plants reveal high taxonomic diversity and unique profiles of secondary metabolites. Front. Microbiol. 2020, 10. [Google Scholar] [CrossRef] [PubMed]
- Li, Y.L.; Xin, X.M.; Chang, Z.Y.; Shi, R.J.; Miao, Z.M.; Ding, J.; Hao, G.P. The endophytic fungi of Salvia miltiorrhiza Bunge.f. alba are a potential source of natural antioxidants. Bot. Stud. 2015, 56, 5. [Google Scholar] [CrossRef] [PubMed]
- Mohamed El-Bondkly, A.A.; El-Gendy, M.M.A.A.; El-Bondkly, E.A.M.; Ahmed, A.M. Biodiversity and biological activity of the fungal microbiota derived from the medicinal plants Salvia aegyptiaca L. and Balanties aegyptiaca L. Biocatal. Agric. Biotechnol. 2020, 28, 101720. [Google Scholar] [CrossRef]
- Jingfeng, L.; Linyun, F.; Ruiya, L.; Xiaohan, W.; Haiyu, L.; Ligang, Z. Endophytic fungi from medicinal herb Salvia miltiorrhiza Bunge and their antimicrobial activity. Afr. J. Microbiol. Res. 2013, 7, 5343–5349. [Google Scholar] [CrossRef]
- Zhou, L.S.; Tang, K.; Guo, S.X. The plant growth-promoting fungus (PGPF) Alternaria sp. A13 markedly enhances Salvia miltiorrhiza root growth and active ingredient accumulation under greenhouse and field conditions. Int. J. Mol. Sci. 2018, 19, 270. [Google Scholar] [CrossRef]
- Wang, X.Z.; Luo, X.H.; Xiao, J.; Zhai, M.M.; Yuan, Y.; Zhu, Y.; Crews, P.; Yuan, C.S.; Wu, Q.X. Pyrone derivatives from the endophytic fungus Alternaria tenuissima SP-07 of Chinese herbal medicine Salvia przewalskii. Fitoterapia 2014, 99, 184–190. [Google Scholar] [CrossRef]
- Ma, C.; Jiang, D.; Wei, X. Mutation breeding of Emericella foeniculicola TR21 for improved production of tanshinone IIA. Process Biochem. 2011, 46, 2059–2063. [Google Scholar] [CrossRef]
- Zhai, X.; Luo, D.; Li, X.; Han, T.; Jia, M.; Kong, Z.; Ji, J.; Rahman, K.; Qin, L.; Zheng, C. Endophyte Chaetomium globosum D38 promotes bioactive constituents accumulation and root production in Salvia miltiorrhiza. Front. Microbiol. 2018, 8, 2694. [Google Scholar] [CrossRef]
- Yang, S.X.; Zhao, W.T.; Chen, H.Y.; Zhang, L.; Liu, T.K.; Chen, H.P.; Yang, J.; Yang, X.L. Aureonitols A and B, Two New C13-Polyketides from Chaetomium globosum, an endophytic fungus in Salvia miltiorrhiza. Chem. Biodivers. 2019, 16, e1900364. [Google Scholar] [CrossRef]
- Debbab, A.; Aly, A.H.; Edrada-Ebel, R.A.; Müller, W.E.G.; Mosaddak, M.; Hakiki, A.; Ebel, R.; Proksch, P. Bioactive secondary metabolites from the endophytic fungus Chaetomium sp. isolated from Salvia officinalis growing in Morocco. Biotechnol. Agron. Soc. Environ. 2009, 13, 229–234. [Google Scholar]
- Mallouk, S.; Mohamed, N.S.E.D.; Debbab, A. Cytotoxic hydroperoxycochliodinol derivative from endophytic Chaetomium sp. isolated from Salvia officinalis. Chem. Nat. Compd. 2020, 56, 701–705. [Google Scholar] [CrossRef]
- Zhao, W.T.; Liu, Q.P.; Chen, H.Y.; Zhao, W.; Gao, Y.; Yang, X.L. Two novel eremophylane acetophenone conjugates from Colletotrichum gloeosporioides, an endophytic fungus in Salvia miltiorrhiza. Fitoterapia 2020, 141, 104474. [Google Scholar] [CrossRef]
- Sang, X.; Guo, J.; Bai, L. Isolation, identification and analysis of secondary metabolites of multidrug-resistance inhibiting endophytic fungi of Salvia miltiorrhiza Bunge. Chin. J. Appl. Environ. Biol. 2014, 20, 621–628. [Google Scholar] [CrossRef]
- Li, X.; Zhai, X.; Shu, Z.; Dong, R.; Ming, Q.; Qin, L.; Zheng, C. Phoma glomerata D14: An endophytic fungus from Salvia miltiorrhiza that produces salvianolic acid C. Curr. Microbiol. 2016, 73, 31–37. [Google Scholar] [CrossRef]
- Tang, K.; Li, B.; Guo, S. An active endophytic fungus promoting growth and increasing salvianolic acid content of Salvia miltiorrhiza. Mycosystema 2014, 33, 594–600. [Google Scholar]
- Chen, H.-M.; Wu, H.-X.; He, X.-Y.; Zhang, H.-H.; Miao, F.; Liang, Z.-S. Promoting tanshinone synthesis of Salvia miltiorrhiza root by a seed endophytic fungus, Phoma herbarum D603. China J. Chin. Mater. Medica 2020, 45, 65–71. [Google Scholar] [CrossRef]
- Zhao, W.-T.; Shi, X.; Xian, P.-J.; Feng, Z.; Yang, J.; Yang, X.-L. A new fusicoccane diterpene and a new polyene from the plant endophytic fungus Talaromyces pinophilus and their antimicrobial activities. Nat. Prod. Res. 2019, 1–7. [Google Scholar] [CrossRef]
- Ming, Q.; Han, T.; Li, W.; Zhang, Q.; Zhang, H.; Zheng, C.; Huang, F.; Rahman, K.; Qin, L. Tanshinone IIA and tanshinone i production by Trichoderma atroviride D16, an endophytic fungus in Salvia miltiorrhiza. Phytomedicine 2012, 19, 330–333. [Google Scholar] [CrossRef]
- Schulz, M.; Knop, M.; Muellenborn, C.; Steiner, U. Root-associated microorganisms prevent caffeine accumulation in shoots of Salvia officinalis L. Int. J. Agric. For. 2013, 3, 152–158. [Google Scholar] [CrossRef]
- Huang, L.; Li, F.; Liu, R.; Guo, J.; Yang, Z.; Bai, L. Antifungal activity of an endophytic strain of Phomopsis sp. on Sclerotinia sclerotiorum, the causal agent of Sclerotinia disease. J. Plant Pathol. 2019, 101, 521–528. [Google Scholar] [CrossRef]
- Tian, J.; Fu, L.; Zhang, Z.; Dong, X.; Xu, D.; Mao, Z.; Liu, Y.; Lai, D.; Zhou, L. Dibenzo-α-pyrones from the endophytic fungus Alternaria sp. Samif01: Isolation, structure elucidation, and their antibacterial and antioxidant activities. Nat. Prod. Res. 2017, 31, 387–396. [Google Scholar] [CrossRef]
- Lou, J.; Yu, R.; Wang, X.; Mao, Z.; Fu, L.; Liu, Y.; Zhou, L. Alternariol 9-methyl ether from the endophytic fungus Alternaria sp. Samif01 and its bioactivities. Brazilian J. Microbiol. 2016, 47, 96–101. [Google Scholar] [CrossRef] [PubMed]
- Lai, D.; Li, J.; Zhao, S.; Gu, G.; Gong, X.; Proksch, P.; Zhou, L. Chromone and isocoumarin derivatives from the endophytic fungus Xylomelasma sp. Samif07, and their antibacterial and antioxidant activities. Nat. Prod. Res. 2019. [Google Scholar] [CrossRef] [PubMed]
- Gupta, S.; Chaturvedi, P.; Kulkarni, M.G.; Van Staden, J. A critical review on exploiting the pharmaceutical potential of plant endophytic fungi. Biotechnol. Adv. 2020, 39, 107462. [Google Scholar] [CrossRef] [PubMed]
- Sacramento, C.Q.; Marttorelli, A.; Fintelman-Rodrigues, N.; De Freitas, C.S.; De Melo, G.R.; Rocha, M.E.N.; Kaiser, C.R.; Rodrigues, K.F.; Da Costa, G.L.; Alves, C.M.; et al. Aureonitol, a fungi-derived tetrahydrofuran, inhibits influenza replication by targeting its surface glycoprotein hemagglutinin. PLoS ONE 2015, 10, e0142246. [Google Scholar] [CrossRef]
- Fatima, N.; Muhammad, S.A.; Khan, I.; Qazi, M.A.; Shahzadi, I.; Mumtaz, A.; Hashmi, M.A.; Khan, A.K.; Ismail, T. Chaetomium endophytes: A repository of pharmacologically active metabolites. Acta Physiol. Plant. 2016, 38, 136. [Google Scholar] [CrossRef]
- Eram, D.; Arthikala, M.K.; Melappa, G.; Santoyo, G. Alternaria species: Endophytic fungi as alternative sources of bioactive compounds. Ital. J. Mycol. 2018, 47, 40–54. [Google Scholar] [CrossRef]
- Wheeler, M.H.; Stipanovic, R.D.; Puckhaber, L.S. Phytotoxicity of equisetin and epi-equisetin isolated from Fusarium equiseti and F. pallidoroseum. Mycol. Res. 1999, 103, 967–973. [Google Scholar] [CrossRef]
- Arnone, A.; Assante, G.; Nasini, G.; Strada, S.; Vercesi, A. Cryphonectric acid and other minor metabolites from a hypovirulent strain of Cryphonectria parasitica. J. Nat. Prod. 2002, 65, 48–50. [Google Scholar] [CrossRef]
- Nicoletti, R. Antitumor and Immunomodulatory Compounds from Fungi. In Reference Module in Life Sciences (Planned for Publication in Encyclopaedia of Mycology); Zaragoza, O., Ed.; Elsevier: Amsterdam, The Netherlands, 2020. [Google Scholar]
- Fitton, A.; Goa, K.L. Azelaic acid: A review of its pharmacological properties and therapeutic efficacy in acne and hyperpigmentary skin disorders. Drugs 1991, 41, 780–798. [Google Scholar] [CrossRef] [PubMed]
- Kachroo, A.; Robin, G.P. Systemic signaling during plant defense. Curr. Opin. Plant Biol. 2013, 16, 527–533. [Google Scholar] [CrossRef] [PubMed]
- Chandra, S. Endophytic fungi: Novel sources of anticancer lead molecules. Appl. Microbiol. Biotechnol. 2012, 95, 47–59. [Google Scholar] [CrossRef] [PubMed]
- Tiwari, P.; Bae, H. Horizontal gene transfer and endophytes: An implication for the acquisition of novel traits. Plants 2020, 9, 305. [Google Scholar] [CrossRef]
- Nützmann, H.W.; Osbourn, A. Gene clustering in plant specialized metabolism. Curr. Opin. Biotechnol. 2014, 26, 91–99. [Google Scholar] [CrossRef]
- Holder, C.L.; Churchwell, M.I.; Doerge, D.R. Quantification of soy isoflavones, genistein and daidzein, and conjugates in rat blood using LC/ES-MS. J. Agric. Food Chem. 1999, 47, 3764–3770. [Google Scholar] [CrossRef]
- Song, T.T.; Hendrich, S.; Murphy, P.A. Estrogenic activity of glycitein, a soy isoflavone. J. Agric. Food Chem. 1999, 47, 1607–1610. [Google Scholar] [CrossRef]
- Zhou, J.Y.; Zhou, S.W. Trigonelline: A plant alkaloid with therapeutic potential for diabetes and central nervous system disease. Curr. Med. Chem. 2012, 19, 3523–3531. [Google Scholar] [CrossRef]
- Tang, W.; Eisenbrand, G. Salvia miltiorrhiza Bge. In Chinese Drugs of Plant Origin; Springer: Berlin/Heidelberg, Germany, 1992. [Google Scholar]
- Su, C.-Y.; Ming, Q.-L.; Rahman, K.; Han, T.; Qin, L.-P. Salvia miltiorrhiza: Traditional medicinal uses, chemistry, and pharmacology. Chin. J. Nat. Med. 2015, 13, 163–182. [Google Scholar] [CrossRef]
- Lu, S. Compendium of Plant Genomes; Springer Nature: Cham, Switzerland, 2019; ISBN 978-3-030-24715-7. [Google Scholar]
- Lu, Y.; Foo, L.Y. Rosmarinic acid derivatives from Salvia officinalis. Phytochemistry 1999, 51, 91–94. [Google Scholar] [CrossRef]
- Lu, Y.; Foo, L.Y.; Wong, H. Sagecoumarin, a novel caffeic acid trimer from Salvia officinalis. Phytochemistry 1999, 52, 1149–1152. [Google Scholar] [CrossRef]
- Radtke, O.A.; Yeap Foo, L.; Lu, Y.; Kiderlen, A.F.; Kolodziej, H. Evaluation of sage phenolics for their antileishmanial activity and modulatory effects on interleukin-6, interferon and tumour necrosis factor-α-release in RAW 264.7 Cells. Zeitschrift Naturforsch. Sect. C J. Biosci. 2003, 58, 395–400. [Google Scholar] [CrossRef] [PubMed]
- Lima, V.N.; Oliveira-Tintino, C.D.M.; Santos, E.S.; Morais, L.P.; Tintino, S.R.; Freitas, T.S.; Geraldo, Y.S.; Pereira, R.L.S.; Cruz, R.P.; Menezes, I.R.A.; et al. Antimicrobial and enhancement of the antibiotic activity by phenolic compounds: Gallic acid, caffeic acid and pyrogallol. Microb. Pathog. 2016, 99, 56–61. [Google Scholar] [CrossRef] [PubMed]
- Zhang, Y.; Jiang, P.; Ye, M.; Kim, S.H.; Jiang, C.; Lü, J. Tanshinones: Sources, pharmacokinetics and anti-cancer activities. Int. J. Mol. Sci. 2012, 13, 13621–13666. [Google Scholar] [CrossRef] [PubMed]
- Zhong, G.-X.; Li, P.; Zeng, L.-J.; Guan, J.; Li, D.-Q.; Li, S.-P. Chemical characteristics of Salvia miltiorrhiza (Danshen) collected from different locations in China. J. Agric. Food Chem. 2009, 57, 6879–6887. [Google Scholar] [CrossRef]
- Ślusarczyk, S.; Topolski, J.; Domaradzki, K.; Adams, M.; Hamburger, M.; Matkowski, A. Isolation and fast selective determination of nor-abietanoid diterpenoids from Perovskia atriplicifolia roots using LC-ESI-MS/MS with multiple reaction monitoring. Nat. Prod. Commun. 2015, 10, 1149–1152. [Google Scholar] [CrossRef]
- Senol, F.S.; Ślusarczyk, S.; Matkowski, A.; Pérez-Garrido, A.; Girón-Rodríguez, F.; Cerón-Carrasco, J.P.; den-Haan, H.; Peña-García, J.; Pérez-Sánchez, H.; Domaradzki, K.; et al. Selective in vitro and in silico butyrylcholinesterase inhibitory activity of diterpenes and rosmarinic acid isolated from Perovskia atriplicifolia Benth. and Salvia glutinosa L. Phytochemistry 2017, 133, 33–44. [Google Scholar] [CrossRef]
- Ślusarczyk, S.; Deniz, F.S.S.; Abel, R.; Pecio, Ł.; Pérez-Sánchez, H.; Cerón-Carrasco, J.P.; Den-Haan, H.; Banerjee, P.; Preissner, R.; Krzyżak, E.; et al. Norditerpenoids with selective anti-cholinesterase activity from the roots of Perovskia atriplicifolia Benth. Int. J. Mol. Sci. 2020, 21, 4475. [Google Scholar] [CrossRef]
- Miroliaei, M.; Aminjafari, A.; Ślusarczyk, S.; Nawrot-Hadzik, I.; Rahimmalek, M.; Matkowski, A. Inhibition of glycation-induced cytotoxicity, protein glycation, and activity of proteolytic enzymes by extract from Perovskia atriplicifolia roots. Pharmacogn. Mag. 2017, 13 (Suppl. 3), S676–S683. [Google Scholar] [CrossRef]
- Liu, J.J.; Liu, W.-D.; Yang, H.Z.; Zhang, Y.; Fang, Z.G.; Liu, P.Q.; Lin, D.J.; Xiao, R.Z.; Hu, Y.; Wang, C.Z.; et al. Inactivation of PI3k/Akt signaling pathway and activation of caspase-3 are involved in tanshinone I-induced apoptosis in myeloid leukemia cells in vitro. Ann. Hematol. 2010, 89, 1089–1097. [Google Scholar] [CrossRef]
- Su, C.-C.; Chen, G.-W.; Lin, J.-G. Growth inhibition and apoptosis induction by tanshinone I in human colon cancer Colo 205 cells. Int. J. Mol. Med. 2008, 22, 613–618. [Google Scholar] [CrossRef] [PubMed]
- Kim, J.Y.; Kim, K.M.; Nan, J.X.; Zhao, Y.Z.; Park, P.H.; Lee, S.J.; Sohn, D.H. Induction of apoptosis by tanshinone I via cytochrome c release in activated hepatic stellate cells. Pharmacol. Toxicol. 2003, 92, 195–200. [Google Scholar] [CrossRef] [PubMed]
- Lee, C.Y.; Sher, H.F.; Chen, H.W.; Liu, C.C.; Chen, C.H.; Lin, C.S.; Yang, P.C.; Tsay, H.S.; Chen, J.J.W. Anticancer effects of tanshinone I in human non-small cell lung cancer. Mol. Cancer Ther. 2008, 7, 3527–3538. [Google Scholar] [CrossRef] [PubMed]
- Nizamutdinova, I.T.; Lee, G.W.; Lee, J.S.; Cho, M.K.; Son, K.H.; Jeon, S.J.; Kang, S.S.; Kim, Y.S.; Lee, J.H.; Seo, H.G.; et al. Tanshinone I suppresses growth and invasion of human breast cancer cells, MDA-MB-231, through regulation of adhesion molecules. Carcinogenesis 2008, 29, 1885–1892. [Google Scholar] [CrossRef]
- Li, W.; Li, J.; Ashok, M.; Wu, R.; Chen, D.; Yang, L.; Yang, H.; Tracey, K.J.; Wang, P.; Sama, A.E.; et al. A Cardiovascular drug rescues mice from lethal sepsis by selectively attenuating a late-acting proinflammatory mediator, high mobility group box 1. J. Immunol. 2007, 178, 3856–3864. [Google Scholar] [CrossRef]
- Yang, L.; Zou, X.; Liang, Q.; Chen, H.; Feng, J.; Yan, L.; Wang, Z.; Zhou, D.; Li, S.; Yao, S.; et al. Sodium tanshinone IIA sulfonate depresses angiotensin II-induced cardiomyocyte hypertrophy through MEK/ERK pathway. Exp. Mol. Med. 2007, 39, 65–73. [Google Scholar] [CrossRef]
- Fang, Z.Y.; Lin, R.; Yuan, B.X.; Yang, G.D.; Liu, Y.; Zhang, H. Tanshinone IIA downregulates the CD40 expression and decreases MMP-2 activity on atherosclerosis induced by high fatty diet in rabbit. J. Ethnopharmacol. 2008, 115, 217–222. [Google Scholar] [CrossRef]
- Chan, P.; Liu, I.M.; Li, Y.X.; Yu, W.J.; Cheng, J.T. Antihypertension induced by tanshinone IIA isolated from the roots of Salvia miltiorrhiza. Evid. Based Complement. Altern. Med. 2011, 2011, 392627. [Google Scholar] [CrossRef]
- Bi, H.C.; Zuo, Z.; Chen, X.; Xu, C.S.; Wen, Y.Y.; Sun, H.Y.; Zhao, L.Z.; Pan, Y.; Deng, Y.; Liu, P.Q.; et al. Preclinical factors affecting the pharmacokinetic behaviour of tanshinone IIA, an investigational new drug isolated from Salvia miltiorrhiza for the treatment of ischaemic heart diseases. Xenobiotica 2008, 38, 185–222. [Google Scholar] [CrossRef]
- Kapoor, S. Tanshinone II A: A potent, natural anti-carcinogenic agent for the management of systemic malignancies. Chin. J. Integr. Med. 2009, 15, 153. [Google Scholar] [CrossRef][Green Version]
- Wei, X.; Jing, M.; Wang, J.; Yang, X. Preliminary study on Salvia miltiorrhiza Bung endophytic fungus. J. Clin. Pediatr. 2010, 22, 241–246. [Google Scholar]
- Zhang, P.; Lee, Y.; Wei, X.; Wu, J.; Liu, Q.; Wan, S. Enhanced production of tanshinone iia in endophytic fungi Emericella foeniculicola by genome shuffling. Pharm. Biol. 2018, 56, 357–362. [Google Scholar] [CrossRef] [PubMed]
- Sairafianpour, M.; Christensen, J.; Steerk, D.; Budnik, B.A.; Kharazmi, A.; Bagherzadeh, K.; Jaroszewski, J.W. Leishmanicidal, antiplasmodial, and cytotoxic activity of novel diterpenoid 1,2-quinones from Perovskia abrotanoides: New source of tanshinones. J. Nat. Prod. 2001, 64, 1398–1403. [Google Scholar] [CrossRef] [PubMed]
- Yuan, Y.; Lu, H. Effect of gibberellins and its synthetic inhibitor on metabolism of tanshinones. Chin. J. Exp. Tradit. Med. Formulae 2008, 14, 6–8. [Google Scholar]
- Rungsimakan, S.; Rowan, M.G. Terpenoids, flavonoids and caffeic acid derivatives from Salvia viridis L. cvar. Blue Jeans. Phytochemistry 2014, 108, 177–188. [Google Scholar] [CrossRef]
- Xiong, W.D.; Gong, J.; Xing, C. Ferruginol exhibits anticancer effects in OVCAR-3 human ovary cancer cells by inducing apoptosis, inhibition of cancer cell migration and G2/M phase cell cycle arrest. Mol. Med. Rep. 2017, 16, 7013–7017. [Google Scholar] [CrossRef]
- Ulubelen, A.; Öksüz, S.; Kolak, U.; Bozok-Johansson, C.; Celik, C.; Voelter, W. Antibacterial diterpenes from the roots of Salvia viridis. Planta Med. 2000, 66, 458–462. [Google Scholar] [CrossRef]
- Lee, S.-Y.; Choi, D.-Y.; Woo, E.-R. Inhibition of osteoclast differentiation by tanshinones from the root of Salvia miltiorrhiza Bunge. Arch. Pharm. Res. 2005, 28, 909–913. [Google Scholar] [CrossRef]
- Tan, N.; Kaloga, M.; Radtke, O.A.; Kiderlen, A.F.; Öksüz, S.; Ulubelen, A.; Kolodziej, H. Abietane diterpenoids and triterpenoic acids from Salvia cilicica and their antileishmanial activities. Phytochemistry 2002, 61, 881–884. [Google Scholar] [CrossRef]
- Tezuka, Y.; Kasimu, R.; Li, J.X.; Basnet, P.; Tanaka, K.; Namba, T.; Kadota, S. Constituents of roots of Salvia deserta Schang. Chem. Pharm. Bull. 1998, 46, 107–112. [Google Scholar] [CrossRef]
- Jiang, Y.; Wang, L.; Lu, S.; Xue, Y.; Wei, X.; Lu, J.; Zhang, Y. Transcriptome sequencing of Salvia miltiorrhiza after infection by its endophytic fungi and identification of genes related to tanshinone biosynthesis. Pharm. Biol. 2019, 57, 760–769. [Google Scholar] [CrossRef] [PubMed]
- Ming, Q.; Su, C.; Zheng, C.; Jia, M.; Zhang, Q.; Zhang, H.; Rahman, K.; Han, T.; Qin, L. Elicitors from the endophytic fungus Trichoderma atroviride promote Salvia miltiorrhiza hairy root growth and tanshinone biosynthesis. J. Exp. Bot. 2013, 64, 5687–5694. [Google Scholar] [CrossRef] [PubMed]
- Ming, Q.; Dong, X.; Wu, S.; Zhu, B.; Jia, M.; Zheng, C.; Rahman, K.; Han, T.; Qin, L. UHPLC-HRMSn analysis reveals the dynamic metabonomic responses of Salvia miltiorrhiza hairy roots to polysaccharide fraction from Trichoderma atroviride. Biomolecules 2019, 9, 541. [Google Scholar] [CrossRef] [PubMed]
- Wu, J.; Ming, Q.; Zhai, X.; Wang, S.; Zhu, B.; Zhang, Q.; Xu, Y.; Shi, S.; Wang, S.; Zhang, Q.; et al. Structure of a polysaccharide from Trichoderma atroviride and its promotion on tanshinones production in Salvia miltiorrhiza hairy roots. Carbohydr. Polym. 2019, 223, 115125. [Google Scholar] [CrossRef]
- Peng, W.; Ming, Q.L.; Zhai, X.; Zhang, Q.; Rahman, K.; Wu, S.J.; Qin, L.P.; Han, T. Polysaccharide fraction extracted from endophytic fungus Trichoderma atroviride D16 has an influence on the proteomics profile of the Salvia miltiorrhiza hairy roots. Biomolecules 2019, 9, 415. [Google Scholar] [CrossRef]
- Zikmundová, M.; Drandarov, K.; Bigler, L.; Hesse, M.; Werner, C. Biotransformation of 2-benzoxazolinone and 2-hydroxy-1,4-benzoxazin-3-one by endophytic fungi isolated from Aphelandra tetragona. Appl. Environ. Microbiol. 2002, 68, 4863–4870. [Google Scholar] [CrossRef]
- Saunders, M.; Kohn, L.M. Evidence for alteration of fungal endophyte community assembly by host defense compounds. New Phytol. 2009, 182, 229–238. [Google Scholar] [CrossRef]
- Venugopalan, A.; Srivastava, S. Endophytes as in vitro production platforms of high value plant secondary metabolites. Biotechnol. Adv. 2015, 33, 873–887. [Google Scholar] [CrossRef]

| Endophyte 1 | Plant Species/Organ | Location, Country | Reference |
|---|---|---|---|
| Acremonium sclerotigenum | S. abrotanoides/root | Zoshk, Iran | [22] |
| Alternaria alternata | S. miltiorrhiza/flower | Shandong, China | [23] |
| S. aegyptiaca/leaf | Gebel Elba, Egypt | [24] | |
| Alternaria chlamydosporigena | S. abrotanoides/root | Zoshk, Iran | [22] |
| Alternaria sp. | S. miltiorrhiza/root | Beijing, China | [25] |
| S. miltiorrhiza/seed | Northwest China | [21] | |
| S. miltiorrhiza/root, shoot, leaf | Henan, China | [26] | |
| S. abrotanoides/leaf, stem | Wroclaw, Poland | this paper | |
| S. yangii/leaf, stem | Wroclaw, Poland | this paper | |
| Alternaria tenuissima | S. przewalskii/root | Longxi, China | [27] |
| Aspergillus brasiliensis | S. aegyptiaca/leaf | Gebel Elba, Egypt | [24] |
| Aspergillus foeniculicola | S. miltiorrhiza/root | Shaanxi, China | [28] |
| Aspergillus nidulans | S. aegyptiaca/leaf | Gebel Elba, Egypt | [24] |
| Aspergillus niger | S. aegyptiaca/leaf | Gebel Elba, Egypt | [24] |
| Aspergillus sp. | S. miltiorrhiza/root | Beijing, China | [25] |
| S. abrotanoides/leaf | Zoshk, Iran | [22] | |
| Aspergillus terreus | S. aegyptiaca/leaf | Gebel Elba, Egypt | [24] |
| Aureobasidium sp. | S. miltiorrhiza/seed | Northwest China | [21] |
| Cadophora sp. | S. miltiorrhiza/root | Beijing, China | [25] |
| Canariomyces microsporus | S. abrotanoides/leaf | Zoshk, Iran | [22] |
| Cephalosporium acremonium | S. aegyptiaca/leaf | Gebel Elba, Egypt | [24] |
| Chaetomium globosum | S. miltiorrhiza/root | Shanluo, China | [29] |
| S. miltiorrhiza/‘aerial part’ | Shenyang, China | [30] | |
| Chaetomium sp. | S. officinalis/stem | Beni-Mellal, Morocco | [31] |
| Giza, Egypt | [32] | ||
| Cladosporium cladosporioides | S. aegyptiaca/leaf | Gebel Elba, Egypt | [24] |
| Clonostachys rosea | S. miltiorrhiza/root | Beijing, China | [25] |
| Colletotrichum gloeosporioides | S. miltiorrhiza/‘aerial part’ | Shenyang, China | [33] |
| Colletotrichum sp. | S. aegyptiaca/leaf | Gebel Elba, Egypt | [24] |
| S. yangii/leaf | Wroclaw, Poland | this paper | |
| Coniolariella hispanica | S. abrotanoides/root | Kalat, Iran | [22] |
| Curvularia papendorfii | S. aegyptiaca/leaf | Gebel Elba, Egypt | [24] |
| Diaporthe sp. | S. miltiorrhiza/stem | Sichuan, China | [34] |
| S. abrotanoides/stem | Wroclaw, Poland | this paper | |
| S. yangii/stem | Wroclaw, Poland | this paper | |
| Didymella glomerata | S. miltiorrhiza/root | Beijing, China | [25] |
| S. miltiorrhiza/leaf | Shangluo, China | [35] | |
| Didymella pedeiae | S. miltiorrhiza/root | Beijing, China | [25] |
| Filobasidium sp. | S. miltiorrhiza/seed | Northwest China | [21] |
| Fusarium dlaminii | S. abrotanoides/root | Darrud, Iran | [22] |
| Fusarium oxysporum | S. aegyptiaca/leaf | Gebel Elba, Egypt | [24] |
| Fusarium proliferatum | S. miltiorrhiza/root | Shandong, China | [23] |
| Fusarium redolens | S. miltiorrhiza/root | Beijing, China | [25] |
| Fusarium sp. | S. miltiorrhiza/root | Beijing, China | [25] |
| S. abrotanoides/root, stem | Wroclaw, Poland | this paper | |
| S. yangii/root, stem | Wroclaw, Poland | this paper | |
| Juxtiphoma eupyrena | S. miltiorrhiza/root | Beijing, China | [25] |
| Leptosphaeria sp. | S. miltiorrhiza/root | Beijing, China | [25] |
| Neocosmospora solani | S. abrotanoides/root | Kalat, Iran | [22] |
| Niesslia ligustica | S. abrotanoides/root | Darrud, Iran | [22] |
| Paecilomyces sp. | S. miltiorrhiza/root | Beijing, China | [36] |
| Paraphoma radicina | S. abrotanoides/root | Zoshk, Iran | [22] |
| Penicillium canescens | S. abrotanoides/root | Zoshk and Kalat, Iran | [22] |
| Penicillium charlesii | S. abrotanoides/root | Zoshk and Kalat, Iran | [22] |
| Penicillium chrysogenum | S. abrotanoides/root | Zoshk, Iran | [22] |
| Penicillium citrinum | S. aegyptiaca/leaf | Gebel Elba, Egypt | [24] |
| Penicillium commune | S. aegyptiaca/leaf | Gebel Elba, Egypt | [24] |
| Penicillium murcianum | S. abrotanoides/root | Kalat, Iran | [22] |
| Penicillium sp. | S. abrotanoides/root | Zoshk and Kalat, Iran | [22] |
| Pestalotiopsis mangiferae | S. aegyptiaca/leaf | Gebel Elba, Egypt | [24] |
| Petriella setifera | S. miltiorrhiza/root | Beijing, China | [25] |
| Phaeoacremonium rubrigenum | S. abrotanoides/root | Zoshk, Iran | [22] |
| Phoma herbarum | S. miltiorrhiza/seed | China | [37] |
| Psathyrella candolleana | S. abrotanoides/root | Zoshk, Iran | [22] |
| Purpureocillium lilacinum | S. abrotanoides/root | Darrud, Iran | [22] |
| Sarocladium kiliense | S. miltiorrhiza/root | Beijing, China | [25] |
| Schizophyllum commune | S. miltiorrhiza/root | Shandong, China | [23] |
| Simplicillium cylindrosporum | S. abrotanoides/root | Darrud, Iran | [22] |
| Talaromyces pinophilus | S. miltiorrhiza/‘aerial part’ | Shenyang, China | [38] |
| Talaromyces sp. | S. abrotanoides/root | Zoshk and Kalat, Iran | [22] |
| Talaromyces verruculosus | S. abrotanoides/root | Zoshk and Kalat, Iran | [22] |
| Trametes hirsuta | S. miltiorrhiza/root | Shandong, China | [23] |
| Trichocladium griseum | S. aegyptiaca/leaf | Gebel Elba, Egypt | [24] |
| Trichoderma asperellum | S. abrotanoides/root | Zoshk, Iran | [22] |
| Trichoderma atroviride | S. miltiorrhiza/root | Shangluo, China | [39] |
| Trichoderma hamatum | S. officinalis/root | Bonn, Germany | [40] |
| Trichoderma viride | S. aegyptiaca/leaf | Gebel Elba, Egypt | [24] |
| Xylomelasma sp. | S. miltiorrhiza/root | Beijing, China | [25] |
| Secondary Metabolite | Producing Species/Strain | Bioactivity | Reference |
|---|---|---|---|
| N-Acetylanthranilic acid | Penicillium sp. Talaromyces sp. | [22] | |
| Altenuene | Alternaria sp./Samif01 Alternaria tenuissima/SP-07 | [42] [27] | |
| 2-epi-Altenuene | Alternaria sp./Samif01 | [42] | |
| 2-Acetoxy-2-epi-altenuene | Alternaria sp./Samif01 | [42] | |
| 3-epi-Dihydroaltenuene A | Alternaria sp./Samif01 | Radical scavenging | [42] |
| Altenuisol | Alternaria sp./Samif01 | Antibacterial, radical scavenging | [42] |
| Alternariol | Alternaria sp./Samif01 Alternaria tenuissima/SP-07 | Antibacterial | [42] [27] |
| Alternariol-9-methyl ether | Alternaria sp./Samif01 Alternaria tenuissima/SP-07 | Antibacterial, antifungal, antinematodal | [43] [27] |
| 4-Hydroxyalternariol-9-methyl ether | Alternaria sp./Samif01 | Antibacterial, radical scavenging | [42] |
| Aureonitols A–B | Chaetomium globosum/XL-1198 | [30] | |
| Azelaic acid | Penicillium canescens Penicillium charlesii Penicillium sp. Talaromyces sp. Talaromyces verruculosus | [22] | |
| Caffeic acid | Paraphoma radicina Talaromyces sp. Talaromyces verruculosus | [22] | |
| Chaetoglobosins E–F | Chaetomium globosum/XL-1198 | [30] | |
| Chaetomin | Chaetomium sp. | Cytotoxic (L5178Y mouse lymphoma) | [32] |
| Chaetomugilin I | Chaetomium globosum/XL-1198 | [30] | |
| Chaetoquadrin D | Xylomelasma sp./Samif07 | [44] | |
| Chaetoviridin | Chaetomium globosum/XL-1198 | [30] | |
| Cochliodinol, isocochliodinol, hydroperoxycochliodinol | Chaetomium sp. | Cytotoxic (L5178Y mouse lymphoma) | [31,32] |
| Colletotricholides A–B | Colletotrichum gloeosporioides/XL1200 | [33] | |
| Cryptotanshinone | Coniolariella hispanica Paraphoma radicina Penicillium canescens Penicillium murcianum | [22] | |
| Daidzein | Fusarium dlaminii Neocosmospora solani Paraphoma radicina Penicillium canescens | [22] | |
| Diaporthin | Xylomelasma sp./Samif07 | Antibacterial, radical scavenging | [44] |
| 2,6-Dimethyl-5-methoxyl-7-hydroxylchromone | Xylomelasma sp./Samif07 | Antibacterial | [44] |
| Equisetin | Chaetomium globosum/XL-1198 | Antibacterial, antifungal | [30] |
| Ferruginol | Trichoderma atroviride D16 | [39] | |
| Glycitein | Talaromyces sp. | [22] | |
| Griseofulvin | Talaromyces sp. | [22] | |
| 8-Hydroxy-6-methoxy-3-methylisocoumarin | Xylomelasma sp./Samif07 | Antibacterial | [44] |
| 6-Hydroxymethyleugenin, 6-methoxymethyleugenin | Xylomelasma sp./Samif07 | Antibacterial | [44] |
| Indole-3-acetic acid | Penicillium canescens Phoma herbarum D603 Talaromyces sp. | [22] [37] [22] | |
| Indole-3-carboxylic acid, 3-formylindole | Chaetomium sp. | [32] | |
| Isoeugenitol | Xylomelasma sp./Samif07 | Antibacterial, antimycobacterial | [44] |
| Mandelic acid | Paraphoma radicina Talaromyces sp. | [22] | |
| 6-Methoxymellein | Xylomelasma sp./Samif07 | [44] | |
| Nipecotic acid | Penicillium canescens | [22] | |
| Paracetamol (acetaminophen) | Penicillium chrysogenum Penicillium sp. | [22] | |
| Pinophicin A | Talaromyces pinophilus | Antibacterial | [38] |
| Pinophol A | Talaromyces pinophilus | Antibacterial | [38] |
| Salvianolic acid C | Didymella glomerata/D-14 | [35] | |
| Solanapyrones A-C | Alternaria tenuissima/SP-07 | Antibacterial | [27] |
| Solanapyrones P-R | Alternaria tenuissima/SP-07 | Antibacterial | [27] |
| Solanidine | Talaromyces sp. | [22] | |
| Stachydrine | Fusarium dlaminii | [22] | |
| Tanshinone I | Trichoderma atroviride D16 | [39] | |
| Tanshinone IIA | Aspergillus foeniculicola/TR21 Trichoderma atroviride D16 | [28] [39] | |
| Trigonelline | Talaromyces sp. | [22] |
Publisher’s Note: MDPI stays neutral with regard to jurisdictional claims in published maps and institutional affiliations. |
© 2020 by the authors. Licensee MDPI, Basel, Switzerland. This article is an open access article distributed under the terms and conditions of the Creative Commons Attribution (CC BY) license (http://creativecommons.org/licenses/by/4.0/).
Share and Cite
Zimowska, B.; Bielecka, M.; Abramczyk, B.; Nicoletti, R. Bioactive Products from Endophytic Fungi of Sages (Salvia spp.). Agriculture 2020, 10, 543. https://doi.org/10.3390/agriculture10110543
Zimowska B, Bielecka M, Abramczyk B, Nicoletti R. Bioactive Products from Endophytic Fungi of Sages (Salvia spp.). Agriculture. 2020; 10(11):543. https://doi.org/10.3390/agriculture10110543
Chicago/Turabian StyleZimowska, Beata, Monika Bielecka, Barbara Abramczyk, and Rosario Nicoletti. 2020. "Bioactive Products from Endophytic Fungi of Sages (Salvia spp.)" Agriculture 10, no. 11: 543. https://doi.org/10.3390/agriculture10110543
APA StyleZimowska, B., Bielecka, M., Abramczyk, B., & Nicoletti, R. (2020). Bioactive Products from Endophytic Fungi of Sages (Salvia spp.). Agriculture, 10(11), 543. https://doi.org/10.3390/agriculture10110543

